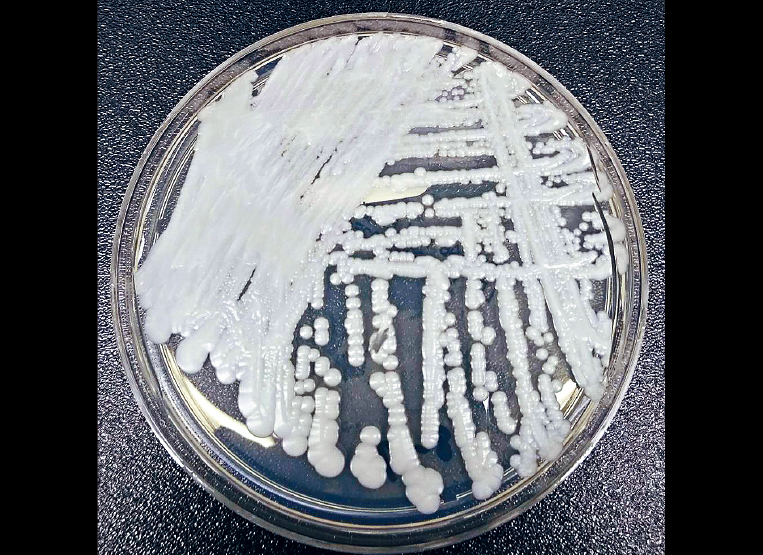

美国疾病控制及预防中心(CDC)官员透露,全美24州以及其他国家多名病人,已在墨西哥2间医院进行整容手术后感染致命真菌,当中2人死亡。为了加强国际关注,美国与墨西哥当局已要求世界卫生组织(WHO),将此列为突发公共卫生事件。
▲美国与墨西哥当局已要求WHO,将感染致命真菌列为突发公共卫生事件。资料图片
CBS报道,涉事的墨西哥医院“河畔手术中心”(River Side Surgical Center)和“Clinica K-3”已经关闭,据悉全美共有195人,曾在这2家医院接受硬膜外麻醉手术,因此CDC正密切关注相关人士的状况。根据墨国当局提供的名单,这些患者中178人来自德州,主要为女性,另外1名男性病人疑似出现脑膜炎症状。此外,还有14名患者属于疑似病例,11人很有可能因大脑或脊髓受感染,继而出现真菌性脑膜炎。CDC于24日发布消息时表示,目前已有2人死亡,6宗潜在病例则被排除。
CDC形容,大多数病人感染真菌后,首先会感到头痛,随后恶化成发烧、呕吐、颈部疼痛、视力模糊等症状,一旦成为脑膜炎,很快便会危及性命。当局表示,今年1月以来曾到上述2家医院进行手术的民众,立即前往区内急诊室或紧急护理机构接受检测。
CDC官员表示,患者往往经中间人介绍,前往这2间位于墨国与德州边界的医院,进行抽脂、隆胸、提臀等外科手术。由于患者遍及美国、墨西哥、加拿大和哥伦比亚,因此希望世卫将其定性为突发公共卫生事件,确保相关国家正视情况并提供信息。
美方尚未确认致病原因,但墨西哥当局在病人脊髓液样本中,发现了镰胞菌属病原真菌(Fusarium solani),去年年底墨西哥爆发致命疫情时,也曾发现了同一真菌,原因也与整容手术有关。
世卫发言人则表示,机构每天都会收到数百宗相关通报,也评估每宗个案,但世卫与成员国家或地区之间的沟通保密,拒绝证实有否收到来自美国的通报。
以上内容归星岛新闻集团所有,未经许可不得擅自转载引用





